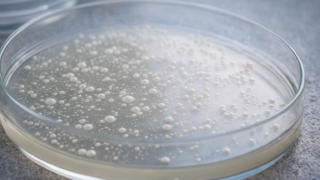

酵母シリーズ
酵母シリーズ 🧫酵母20:酵母から見える世界 ― 目に見えない生命の役割 ―
酵母が食文化、自然界、生態系、科学、産業にどのように関わっているのかを総まとめ。目に見えない微生物が支える世界の姿を丁寧に解説する
 酵母シリーズ
酵母シリーズ  酵母シリーズ
酵母シリーズ  酵母シリーズ
酵母シリーズ  酵母シリーズ
酵母シリーズ  酵母シリーズ
酵母シリーズ  酵母シリーズ
酵母シリーズ  酵母シリーズ
酵母シリーズ  酵母シリーズ
酵母シリーズ 酵母シリーズ
酵母シリーズ  酵母シリーズ
酵母シリーズ